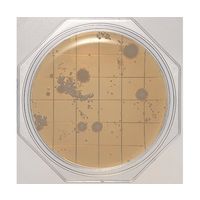
島津ダイアグノスティクス クリーンスタンプ25「ニッスイ」 SCD寒天(一般生菌数測定用) 30枚 06791 1箱(30枚)（直送品）

- メーカー
日水製薬 クリーンスタンプ25「ニッスイ」 SCD寒天(一般生菌数測定用)
日本薬局方準拠培地 環境微生物検査用 一般生菌数測定用
¥8,300 ~ ¥37,950 (税込)
ご注意
特別にお届けに日数がかかるなど、お買い上げにあたってご注意いただきたいことがある商品です。 商品詳細画面に情報が記載してありますのでご購入前に商品詳細画面をぜひご確認ください。
返品不可
お客様のご都合による返品はお受けできません。
直送品
出荷元より直接お届けする商品です。一般商品とは別便でお届けとなります。レジ画面に表示されるのはお届け日の目安です。こちらの商品はお客様都合による返品をお受けできません。